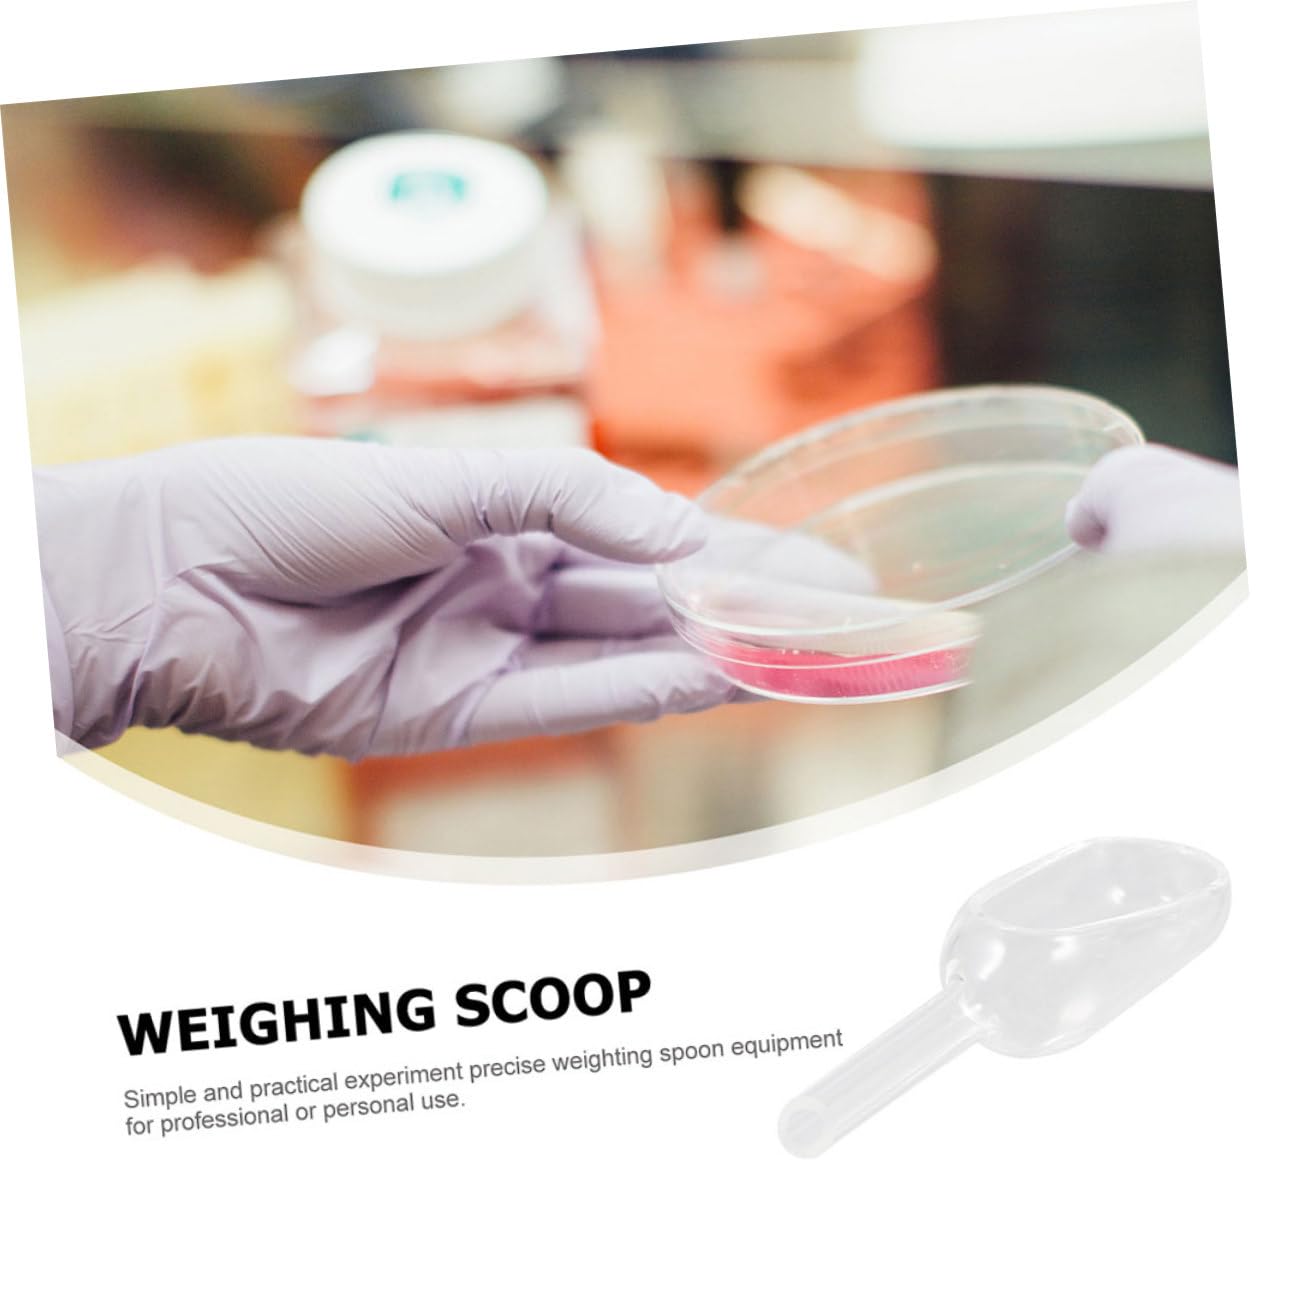
212 Main Open Scoop Square Red

Product Information
Specification
Brand : 212 Main
BulletPoint : 12-PACK of Black Prospector’s Scoop is a must-have for accompanying your metal detector, as well as your panning, treasure hunting, gold prospecting, and gardening supplies. Features of this product include: Heavy-duty plastic material that does not rust or corrode Non-metallic scoop material for easily sensing metal when scanning under a metal detector Black color to help spot any gold among other particles Lanyard hole in the handle provides attachment options Overall length: 12-½”
BulletPoint1 : Color: Red
BulletPoint2 : Material: Plastic
BulletPoint3 : Shape: Square
BulletPoint4 : Weight: 0.5 lbs
BulletPoint5 : Package Quantity: 1
Color : As Shown
ExternallyAssignedProductIdentifier : 3661784102129
ExternallyAssignedProductIdentifier1 : 0742431244751
ExternallyAssignedProductIdentifier2 : 742431244751
ItemDisplayDimensions_Length : 3.35 centimeters
ItemName : 212 Main Open Scoop Square Red
ItemPackageDimensions_Height : 1.97 inches
ItemPackageDimensions_Length : 9.65 inches
ItemPackageDimensions_Width : 3.15 inches
ItemPackageQuantity : 1
ItemTypeKeyword : science-lab-scoops
Manufacturer : PetPride
Material : synthetic material
ModelName : Gold Panning Scoop
ModelNumber : 418T0WBDA35LG923OYQ19M
NumberOfItems : 1
PartNumber : PE3276608
PowerSourceType : hand_powered
ProductDescription : Pet Products has unique directory gives pet lovers local access to the products and services they need for their pets. We provide pet owners a onestop for products, research, reviews, and local information. These products meet the needs of the pet industry to provide data needed to gain insights into the pet market. We are striving to be the largest pet products directory in the world.Manufactured from polyethylin plastic and has a square shape with a pour spout for easy pouring for liquids feed seed etc. Specifications. Color Red. Material Plastic. Shape Square. Weight 0.5 lbs
ProductSiteLaunchDate : 2024-01-23T00:00:00.000-08:00
Size : 8X3X2.5CM
SupplierDeclaredDgHzRegulation : not_applicable
SupplierDeclaredDgHzRegulation1 : not_applicable
SupplierDeclaredDgHzRegulation2 : not_applicable
SupplierDeclaredDgHzRegulation3 : not_applicable
SupplierDeclaredDgHzRegulation4 : not_applicable
SupplierDeclaredDgHzRegulation5 : not_applicable
UnitCount : 1